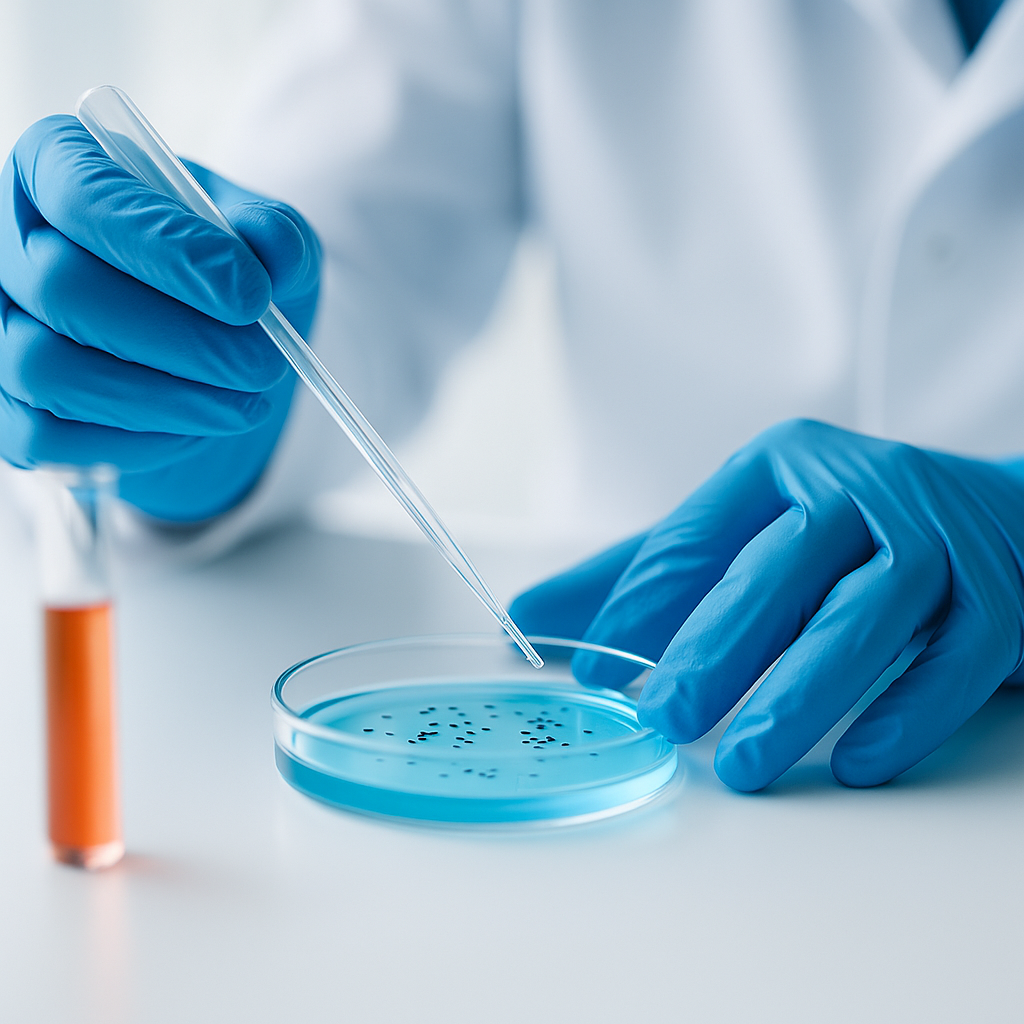

-
Biomedizinische Signalverarbeitung
Hier steht die Elektronik im Mittelpunkt. Sie ist in der Medizintechnik unverzichtbar. Du lernst, wie elektronische Systeme entwickelt und genutzt werden, um biologische Signale wie Herzaktivität und Gehirnströme präzise zu erfassen und zu analysieren. Dieses Wissen ist entscheidend für die Entwicklung moderner Diagnose- und Therapiegeräte in der Medizin.

-
Medizin- und Gesundheitsinformatik
Du arbeitest vorwiegend mit der Programmiersprache Python, entwickelst Datenbanken und verstehst die Funktionsweise von Krankenhausinformationssystemen. Zudem wirst du in der Erstellung von Webapplikationen und Smartphone Apps geschult, die in der modernen Gesundheitsversorgung immer wichtiger werden.

-
Medizin und Gesundheitswesen
In diesem Bereich lernst du die medizinische Fachterminologie, um sicher mit Ärzt*innen und medizinischem Personal zu kommunizieren. Du tauchst in die Molekularbiologie und Immunologie ein, um zu verstehen, wie der Körper funktioniert. Dieser Schwerpunkt ist unerlässlich, um medizinische Geräte in der Praxis richtig einzusetzen und zu verstehen.
-
Medizinische Gerätetechnik
Hier lernst du, wie moderne Medizingeräte funktionieren und in Krankenhäusern und Arztpraxen eingesetzt werden. Du verstehst die Funktionsweise von EKGs, oder Ultraschallsystemen und arbeitest an ihrer Weiterentwicklung. Dabei verbindest du Theorie mit Praxis und leistest so einen wichtigen Beitrag zur Patientenversorgung.

